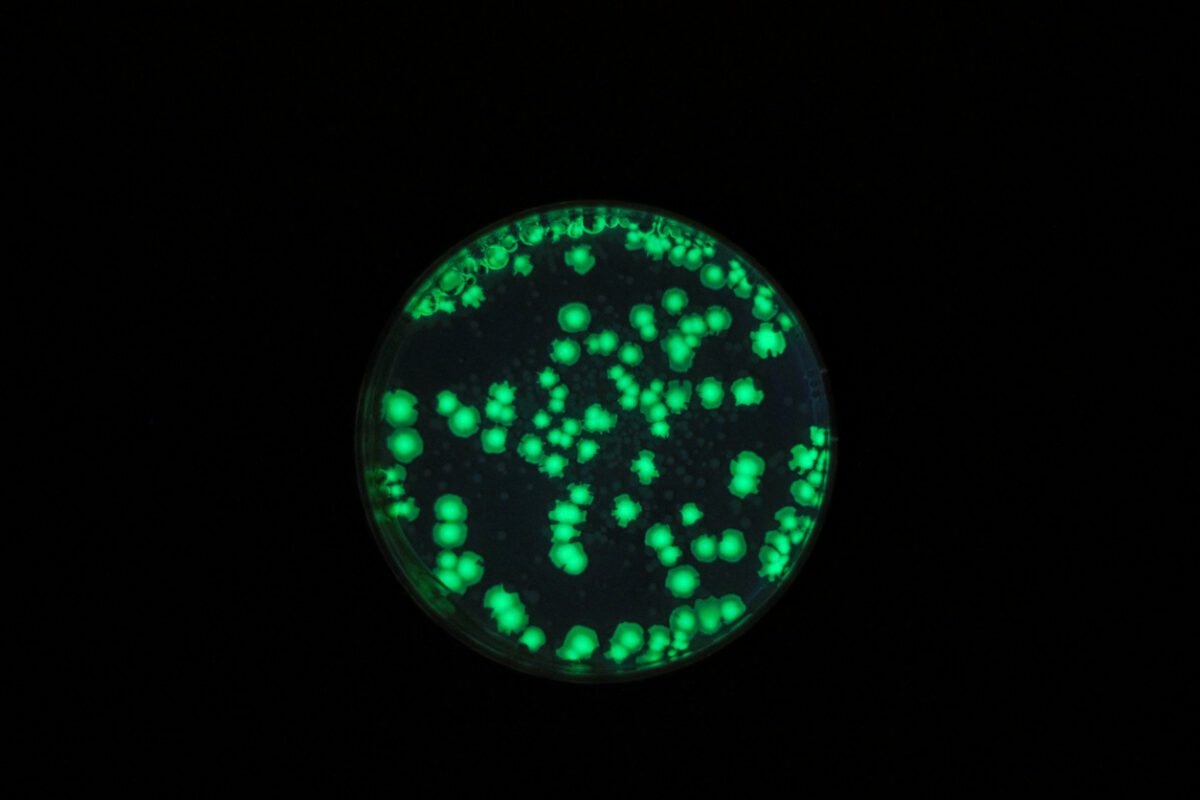

A drug that is already in clinical trials against the hepatitis C virus (HCV) has been shown to be excellent at also preventing the hepatitis E virus (HEV) from replicating.
Up to 70,000 people die each year, globally, from infections with the hepatitis E virus. China manufactures a vaccine against the virus, but it is not widely available elsewhere due to lack of evidence about its success rates. This could change with the identification of bemnifosbuvir as a compound effective against hepatitis E viruses.
An international research team from Germany and China noted that, since the drug is also effective against hepatitis C, and is already in clinical trials demonstrating this, it could also become available as a treatment option against the hepatitis E virus in the future. The team reported their findings in the journal Gut on March 6, 2026.
Hepatitis E is most common in developing countries with an inadequate water supply and poor environmental sanitation. It is most usually spread through the faecal-oral route where contaminated human bodily waste enters the water or food supply.

The faecal-oral route for infection, and how it can be disrupted. [By Gauthami Penakalapati , Jenna Swarthout, Miranda J. Delahoy, Lydia McAliley, Breanna Wodnik, Karen Levy, and Matthew C. Freeman, used under a CC license]
Hepatitis E epidemics involving large numbers of people have been reported in the past in Asia, the Middle East, Africa, and Central America. People living in crowded camps or temporary housing, including refugees and people who are internally displaced, are at particularly high risk. Hepatitis E can also be spread from a pregnant woman to her foetus, and through transfusion of infected blood products. Hepatitis E is an uncommon infection in Australia where most cases are acquired overseas.

The starting point in the search for an active substance against HEV was a commercially available library of nucleotide/nucleoside analogues. “These synthetically produced molecules are constructed similarly to the building blocks of our genetic material and likewise to that of viruses,” explained Dr. Mara Klöhn, one of the study authors.
To find out whether any of the roughly 500 compounds in the library could inhibit HEV replication, the researchers used a genetically engineered version of the virus that contained a molecule that glowed under UV light (an attribute known as fluorescence). They infected cell cultures with this virus, and then added the various candidate compounds. Using fluorescence, they were able to determine whether the virus had continued to replicate or not.
“With bemnifosbuvir we were able to see that the virus no longer replicated, while the treated cells remained healthy,” explained Jungen Hu, another author of the study. In animal experiments, the Chinese researchers were able to confirm the efficacy of the substance against HEV and liver inflammation. Now, if the ongoing clinical trials of bemnifosbuvir against hepatitis C are successful, the researchers say the drug could soon also be available for off-label use against hepatitis E.
Further Reading:
- Current global estimates, risk factors, and knowledge gaps for Hepatitis E virus (HEV): A scoping review (PLoS Negl Trop Dis. 2026 Mar 11;20(3):e0013980. doi: 10.1371/journal.pntd.0013980)
- The global burden of hepatitis E virus genotypes 1 and 2 in 2005 (Hepatology 55(4):p 988-997, April 2012. | DOI: 10.1002/hep.25505)
- Hepatitis E vaccine: WHO position paper, May 2015 (DOI: 10.1016/j.vaccine.2015.07.056)
Last updated 24 April 2026
More from:
Enjoyed this article? Subscribe to be notified whenever we publish new stories.
Subscribe for Updates





